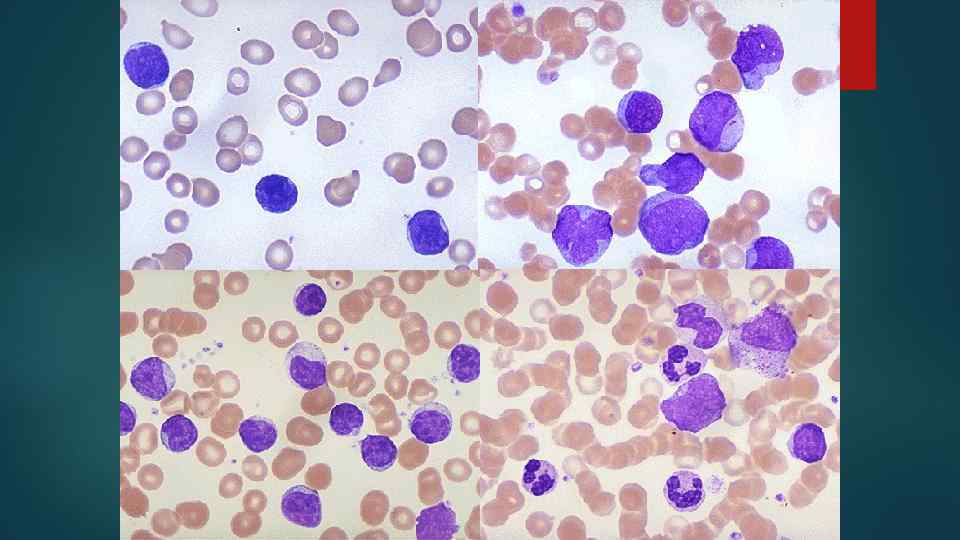
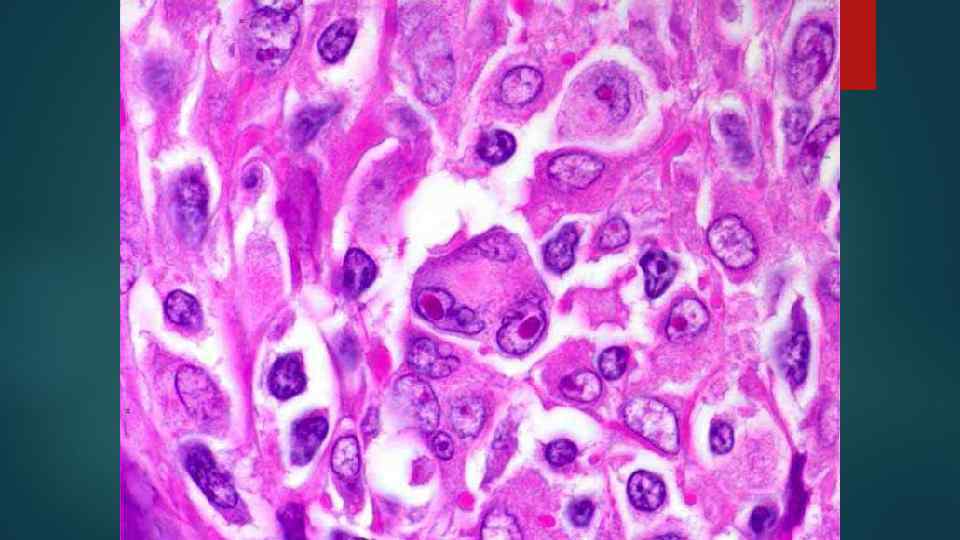
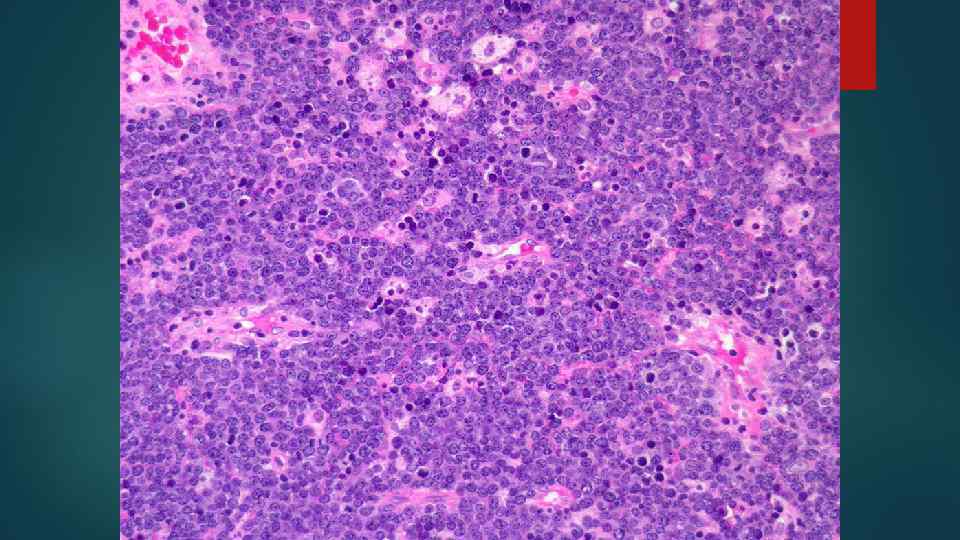

Гемобластозы.pptx
- Количество слайдов: 75

Гемобластозы

Опухоли кроветворной и лимфоидной ткани Лейкемия (лейкоз) – системная опухоль кроветворной ткани Лимфома – регионарная опухоль лимфоидной ткани

Роль генетических факторов С-м Дауна С-м Клайнфельтера С-м Блума С-м Фанкони

Роль иммунологических факторов первичные иммунодефициты (с-мы Вискотта– Олдриджа, атаксии–телеангиоэктазии) вторичные иммунодефициты (цитостатики, лучевая терапия, пересадка органов, ВИЧ)

Роль средовых факторов физические (ионизирующая радиация) химические (бензол) вирусы (вирус Т-клеточного лейкоза человека (НTLV –I), вирус Эпштейн-Барра)

Лейкемия (лейкоз) – злокачественная опухоль кроветворной системы, при которой наблюдается неконтролируемая пролиферация атипичных, незрелых кроветворных клеток (лейкемические клетки) в КМ и другой лимфоретикулярной ткани (л/у, селезенка и др. )

Схема кровотворения

Общая характеристика лейкемии 1. Пролиферация атипичного клона гемопоэтических клеток 2. Они происходят из предшественников гранулоцитов, лимфоцитов и моноцитов, но не способны к дифференцировке в нормальные кроветворные клетки 3. Прежде всего поражается костный мозг

КМ в норме и при лейкозе

4. Инфильтрация КМ приводит к подавлению: лейкопоэза тромбоцитопоэза (Тr-пения) эритроцитопоэза (анемия). 5. В большинстве случаев лейкозные клетки поступают в кровь. 6. Лейкозные клетки могут инфильтрировать также печень, селезенку, л/у, любой другой орган и любую ткань.

Морфология лейкемии 1. Лейкемические инфильтраты в КМ, печени, селезенке, л/у и др. органах с их ↑.


2. Проявления анемии 3. Язвенно-некротические процессы в СО: некротическая ангина стоматиты гингивиты язвы в желудке, кишечнике и т. д.


4. Геморрагический синдром Причины: 1. Поражение лейкозными клетками стенок сосудов 2. Тромбоцитопения и анемия 3. Гипофибриногенемия




Лейкемоидные реакции – это реактивные изменения в периферической крови сходные с лейкозными, но лейкемические инфильтраты в органах отсутствуют

Причины лейкемоидных реакций Хронические инфекции (туберкулез) Ревматические болезни Сепсис Метастазы злокачественных опухолей в КМ

Принципы классификации лейкозов 1. Степень дифференцировки опухолевых клеток и характер течения: острый хронический

Острый лейкоз (ОЛ) – субстрат опухоли составляют молодые, очень незрелые, т. е. бластные клетки (бласты)

Хронический лейкоз (ХЛ) – субстрат опухоли составляют морфологически зрелые или близкие к нормальным по зрелости клетки. Количество бластов ↑.

Принципы классификации 2. Количество лейкоцитов в периферической крови: лейкемический сублейкемический лейкопенический алейкемический

Принципы классификации 3. Происхождение (гисто-, цитогенез) опухолевых клеток.

Общая характеристика острых (ОЛ) и хронических лейкозов(ХЛ) ОЛ ХЛ 1. Молодой дети возраст, 2. Лейкемический провал Средний и пожилой возраст 2. Наличие всех форм кроветворных клеток, но бласты превышают норму 1.

Общая характеристика ОЛ и ХЛ ОЛ 3. Геморрагический синдром. Язвеннонекротические процессы в СО 4. печени, селезенки, л/у выражено не очень значительно ХЛ 3. Чаще возникают при обострении (бластный криз) 4. Значительное печени, селезенки, л/у

Классификация ОЛ Недифференцированный Миелобластный Лимфобластный Монобластный Эритромиелобластный Мегакариобластный

Основные морфологические проявления ОЛ пиоидный КМ ОЛЛ 85% – у детей ОМЛ 85 % – у взрослых малиново-красный Л/у селезенка печень КМ Тимус мочевая система кожа очень характерен нейролейкоз Лейкемические инфильтраты КМ селезенка печень Л/у СО ЖКТ (полость рта, зев, миндалины, желудок) легкие – 1/3 (пневмонит) оболочки мозга – ¼ (нейролейкоз)

Проявления нейролейкоза Лейкемическая инфильтрация мозговой оболочки. мягкой Локолизация: паутинная оболочка, вирхов– робеновские пространства.

Лейкемические инфильтраты окружают сосуды, блокируют пути ликворооттока внутричерепная гипертензия. В ликворе выявляются бласты.

FAB (French-American-British) классификация ОЛЛ Различают 3 формы: L 1 –детский тип (80– 88%) – РБ-61% L 2 – взрослый тип (8– 18%) – РБ-26, 5% L 3 – типа Беркитта (1– 3%) Учитывают иммунологическую характеристику лимфоцитов (из Т или В-клеток) Т-клеточные – L 1 и L 2 В-клеточные: Ранний пре-В-клеточный L 1 и L 2(пре-В) пре-В-клеточный L 1 и L 2 В-клеточный –L 3

FAB классификация ОМЛ – острый миелобластный лейкоз МО – с минимальной дифференцировкой (устойчив к лечению, 5– 10%) М 1 - без дозревания – 10– 20%, чаще у взрослых) М 2 – с дозреванием (все возраста, 35– 40%) М 3 – о. промиелоцитарный – 4 -30% у детей, 5– 10% у взрослых, хромосомная аберрация t (15, 17)

FAB классификация ОМЛ – острый миелобластный лейкоз М 4 – о. миеломоноцитарный (все возрасты, 15– 20%) М 5 – о. моноцитарный (4– 5%, дети, и до 25 лет) М 6 – о. эритромиелоз (5%. для детей не характерен) М 7 – о. мегакариобластный (8– 10%, для детей не характерен)

Причины смерти при ОЛ 1. Кровоизлияния в жизненно важные органы 2. Осложнения, связанные с некротически-язвенными процессами 3. Присоединение инфекции 4. Угнетение функции КМ 5. Осложнения терапии

Хронические лейкозы Миелоцитарного происхождения Лимфоцитарного происхождения Ø Хронический миелоидный лейкоз (ХМЛ) Ø Хронический эритромиелоз Ø Эритремия Ø Ø Ø Истинная полицитемия (болезнь Вакеза – Ослера) Ø Хронический лимфолейкоз (ХЛЛ) Лимфоматоз кожи (болезнь Сезари) Парапротеинемические лейкозы

Основные морфологические проявления ХЛ Заболевание Признак Возраст Наличие Рh-хромосомы КМ грудины Хр. миелоидный лейкоз Хр. лимфоидный лейкоз 30 -40 лет 40 -60 лет (у детей не бывает) + – пиоидный малиново-красный резкое ↑ селезенки резкое ↑ л/у


Лейкемические инфильтраты (расположение) Орган ХМЛ ХЛЛ Селезенка пульпа фолликулы с увеличением резким их Печень по ходу капсулы, в синусоидах капсула, портальные тракты, образование лимфом Легкие по ходу альвеолярных перегородок перибронхиально Характерны • лейкемические тромбы в сосудах многих органов (инфаркты) • бластные кризисы • лейкемические тромбы не характерны • инфекционные осложнения, гемолитическая анемия (гемосидероз), Тр-пения


Причины смерти при ХЛ 1. Присоединение инфекции 2. Дисфункция органов. 3. При л/у – сдавление жизненно важных органов 4. Осложнения стероидной, цитостатической терапии

Причины смерти при ХЛ 1. Присоединение инфекции 2. Дисфункция органов. 3. При л/у – сдавление жизненно важных органов 4. Осложнения стероидной, цитостатической терапии

Лимфомы – это злокачественные новообразования лимфоидной ткани, которые могут первично возникать в л/у или экстранодально.


Общая характеристика лимфом л/у Морфология: стирание рисунка л/у Часто имеются общие симптомы интоксикации (лихорадка > 38, профузный ночной пот, ↓массы тела) Могут лейкемизироваться (> 25 % бластов в КМ)




Классификация лимфом 1. По морфологии: Лимфома Ходжкина (ХЛ) Неходжкинские лимфомы (НХЛ)

2. По распространенности: Локализованные – поражение л/у или какого-то 1 органа (желудок, легкие и др. ) Генерализованные – поражение л/у, селезенки, печени, КМ и др. органов

Лимфома Ходжкина (ХЛ) Синонимы: болезнь Ходжкина, лимфогранулематоз (ЛГМ) Возрастные пики заболеваемости: больные 15– 34 лет и > 55 лет

ХЛ Характерно постепенное вовлечение л/у: шейные, средостение, подвздошная область и т. д. Клеточный Прогноз состав опухоли полиморфен благоприятнее, чем при НХЛ Порфировая селезенка

Виды опухолевых клеток 1. Малые и большие клетки Ходжкина 2. Клетки Рид – Березовского – Штернберга (РШ-клетки) классические popcorn лакунарные

Гистологические варианты ХЛ 1. C лимфоидным преобладанием 2. Смешанноклеточный 3. С нодулярным склерозом 4. С лимфоидным истощением

Причины смерти при ХЛ 1. Сдавление жизненно важных органов увеличенными л/у 2. Присоединение инфекции 3. Кахексия 4. Амилоидоз 5. Дисфункция органов

Неходжкинская лимфома (НХЛ)

Отличия ХЛ от НХЛ ХЛ НХЛ Одновременное вовлечение в процесс л/у разных локализаций Сначала л/у (или узел) одного региона (шейные) Мономорфизм клеток Полиморфизм клеток Возникает чаще после 40 лет Возраст начала – чаще у детей и молодых Прогноз хуже Прогноз лучше (80% у детей вылечивается)



Принципы классификации НХЛ 1. 2. 3. 4. 5. Размеры и морфология клеток По степени дифференцировки Происхождение (Т- и В- клеточные) Распространенность в л/у По степени злокачественности и прогнозу: а) вялотекущие б) агрессивные в) высокоагрессивные


Лимфома Беркитта Высокозлокачественная В-клеточная эндемический и спорадический варианты. лимфома, имеющая • Эндемическая лимфома Беркитта: лимфома, возникающая у детей преимущественно в экваториальной Африке, строго ассоциированная с вирусом Эпштейна–-Барр и характерной транслокацией гена MYC. • Спорадическая лимфома Беркитта: лимфома, возникающая у более старших пациентов по всему миру, также ассоциированная с транслокацией гена MYC, но меньше с вирусом Эпстайна–-Барр.

Гистологическая картина: Монотонные поля клеток с грубым хроматином и выраженными ядрышками. Картина «звездного неба» - на фоне темных лимфомных клеток выделяются гистиоциты с фрагментами ядер погибших лимфомных клеток в бледной цитоплазме

Парапротеинемические лейкозы Миеломная болезнь (болезнь Рустицкого – Калера) Первичная макроглобулинемия Вальденстрема Болезнь тяжелых цепей Франклина

Общие признаки парапротеинемических лейкозов 1. амилоидоз (AL-амилоидоз) 2. парапротеинемический отек ( миокард, почки, легкие) – парапротеиноз миокарда, легких, парапротеинемический нефроз 3. синдром повышенной вязкости крови – парапротеинемическая кома

Миеломная болезнь В основе – разрастание опухолевых клеток лимфоплазмоцитарного ряда – миеломных клеток в КМ и вне его. Миеломные клетки секретируют пара-протеины, которые обнаруживаются в крови и моче (белок Бенс – Джонса) Формы в зависимости от характера роста: диффузная, диффузно-узловатая и множественно-узловатая. Формы в зависимости от характера миеломных клеток: плазмоцитарная, плазмобластная, полиморфно-клеточная, мелкоклеточная миеломы.



Гемобластозы.pptx